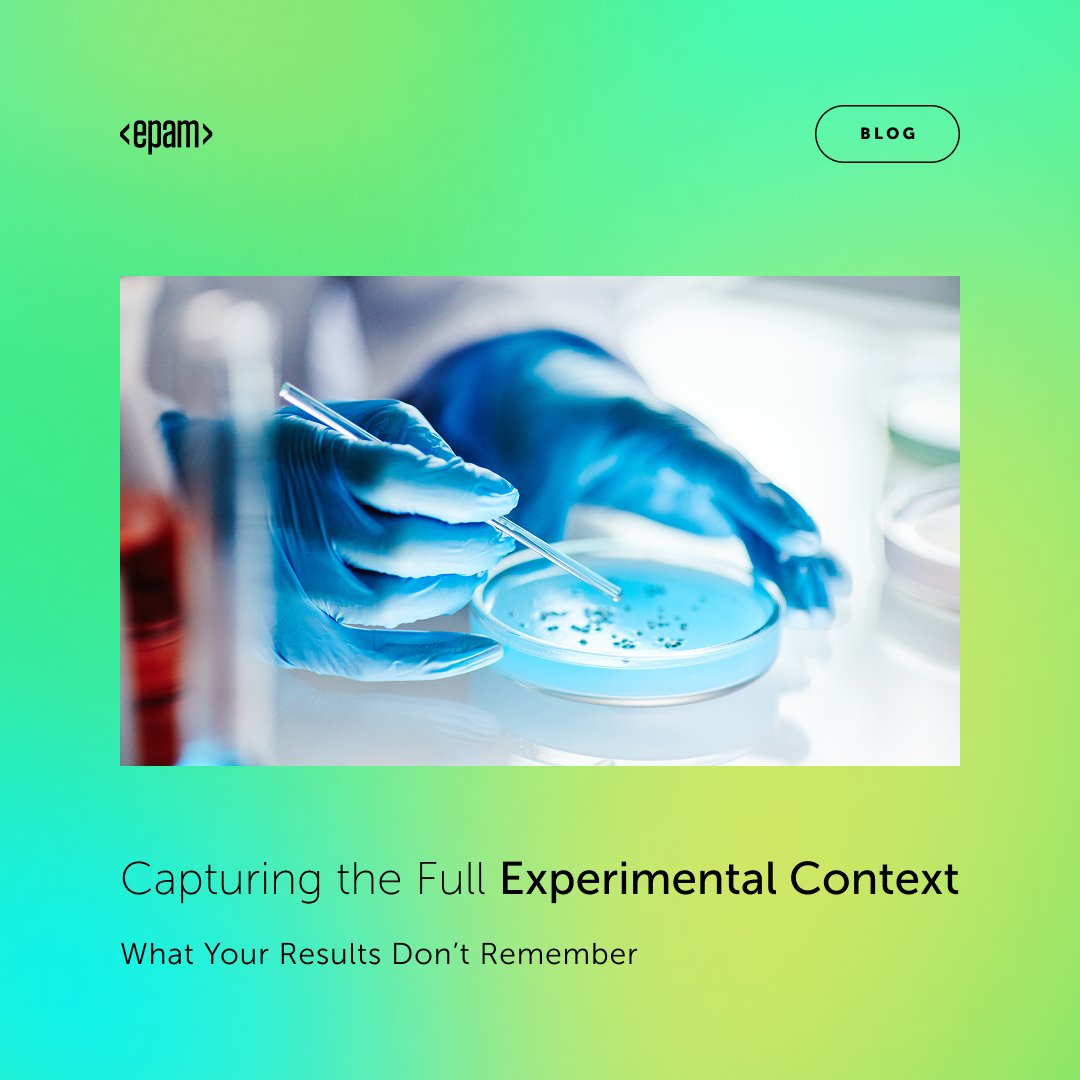
EPAM Systems tweet media

What happens when a forward-thinking company like Nelnet meets EPAM’s #AI expertise? A 31% leap in productivity!
Read our recent case study to learn how Nelnet partnered with EPAM to explore the potential of GenAI tools to boost #PDLC efficiency: ow.ly/c0CE50YKk5g

English